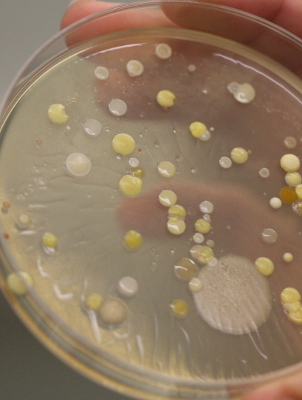

| Darbuotojas | Darbo tel. | El. paštas | Darbo adresas |
|
Kalėdienė Lilija, dr. (HP), |
(8 5) 2398205 |
Šis el.pašto adresas yra apsaugotas nuo šiukšlių. Jums reikia įgalinti JavaScript, kad peržiūrėti jį. | GMC, Saulėtekio al. 7, Vilnius, C-345 kab. |
| Kuisienė Nomeda, dr., prof. katedros vedėja |
(8 5) 2398213 |
Šis el.pašto adresas yra apsaugotas nuo šiukšlių. Jums reikia įgalinti JavaScript, kad peržiūrėti jį. | GMC, Saulėtekio al. 7, Vilnius, C-333 kab. |
| Gegeckas Audrius, dr., Lektorius |
(8 5) 2398209 |
Šis el.pašto adresas yra apsaugotas nuo šiukšlių. Jums reikia įgalinti JavaScript, kad peržiūrėti jį. | GMC, Saulėtekio al. 7, Vilnius, C-341 kab. |
| Gricajeva Alisa, jaunesnioji asistentė |
(8 5) 2398214 |
Šis el.pašto adresas yra apsaugotas nuo šiukšlių. Jums reikia įgalinti JavaScript, kad peržiūrėti jį. | GMC, Saulėtekio al. 7, Vilnius, C-339 kab. |
| Gudiukaitė Renata, dr., lektorė |
(8 5) 2398209 |
Šis el.pašto adresas yra apsaugotas nuo šiukšlių. Jums reikia įgalinti JavaScript, kad peržiūrėti jį. | GMC, Saulėtekio al. 7, Vilnius, C-341 kab. |
| Jurkevičienė Ramunė, administratorė |
(8 5) 2398206 |
Šis el.pašto adresas yra apsaugotas nuo šiukšlių. Jums reikia įgalinti JavaScript, kad peržiūrėti jį. | GMC, Saulėtekio al. 7, Vilnius, C-347 kab. |
| Kananavičiūtė Rūta, dr., asistentė |
(8 5) 2398210 |
Šis el.pašto adresas yra apsaugotas nuo šiukšlių. Jums reikia įgalinti JavaScript, kad peržiūrėti jį. | GMC, Saulėtekio al. 7, Vilnius, C-349 kab. |
| Kaunietis Arnoldas, dr., mokslo darbuotojas |
(8 5) 2398207 |
Šis el.pašto adresas yra apsaugotas nuo šiukšlių. Jums reikia įgalinti JavaScript, kad peržiūrėti jį. | GMC, Saulėtekio al. 7, Vilnius, C-335 kab. |
| Raugalas Juozas, dr., lektorius |
(8 5) 2398208 |
Šis el.pašto adresas yra apsaugotas nuo šiukšlių. Jums reikia įgalinti JavaScript, kad peržiūrėti jį. | GMC, Saulėtekio al. 7, Vilnius, C-337 kab. |
| Čekuolytė Kotryna, doktorantė | (8 5) 2398208 |
Šis el.pašto adresas yra apsaugotas nuo šiukšlių. Jums reikia įgalinti JavaScript, kad peržiūrėti jį. | GMC, Saulėtekio al. 7, Vilnius, C-337 kab. |
| Lastauskienė Eglė, dr., docentė |
(8 5) 2398210 |
Šis el.pašto adresas yra apsaugotas nuo šiukšlių. Jums reikia įgalinti JavaScript, kad peržiūrėti jį. | GMC, Saulėtekio al. 7, Vilnius, C-349 kab. |
| Lekavičiūtė Jolanta, vyriausioji specialistė |
(8 5) 2398214 |
Šis el.pašto adresas yra apsaugotas nuo šiukšlių. Jums reikia įgalinti JavaScript, kad peržiūrėti jį. | GMC, Saulėtekio al. 7, Vilnius, R-324 kab. |
| Petkauskaitė Raimonda, jaunesnioji asistentė |
(8 5) 2398207 |
Šis el.pašto adresas yra apsaugotas nuo šiukšlių. Jums reikia įgalinti JavaScript, kad peržiūrėti jį. | GMC, Saulėtekio al. 7, Vilnius, C-335 kab. |
| Bikmurzin Ruslan, doktorantas | (8 5) 2398207 |
Šis el.pašto adresas yra apsaugotas nuo šiukšlių. Jums reikia įgalinti JavaScript, kad peržiūrėti jį. | GMC, Saulėtekio al. 7, Vilnius, C-335 kab. |
| Malūnavičius Vilius, doktorantas | (8 5) 2398208 |
Šis el.pašto adresas yra apsaugotas nuo šiukšlių. Jums reikia įgalinti JavaScript, kad peržiūrėti jį. | GMC, Saulėtekio al. 7, Vilnius, C-337 kab. |
| Justina Jurgelevičiūtė, doktorantė | (8 5) 2398209 |
Šis el.pašto adresas yra apsaugotas nuo šiukšlių. Jums reikia įgalinti JavaScript, kad peržiūrėti jį. | GMC, Saulėtekio al. 7, Vilnius, C-341 kab. |
| Kirtiklienė Tatjana, doktorantė |
(8 5) 2105496 |
tatjana.kirtiklienė@gmc.vu.lt | GMC, Saulėtekio al. 7, Vilnius, C-335 kab. |